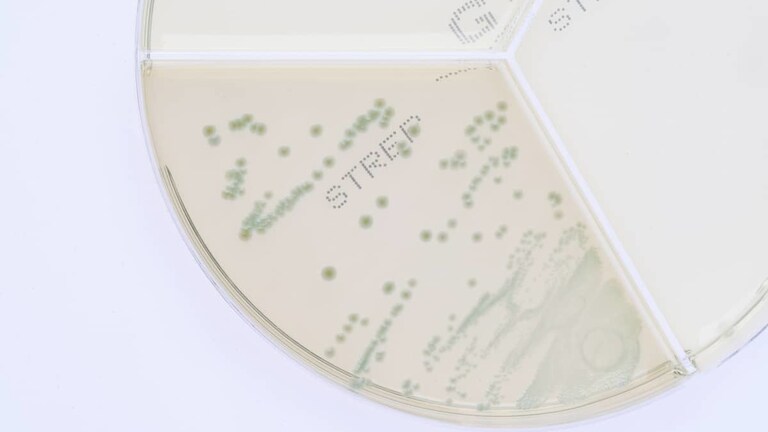

Streptococcus agalactiae gehört zu den wichtigen infektiösen Erregern der Mastitis bei Milchkühen, ist gut an die Milchdrüse angepasst und weist eine hohe Affinität zu Milch auf. Im Außenbereich vermehrt er sich nicht, kann aber mehrere Wochen lang überleben.
Infektionsquellen sind andere infizierte Milchdrüsen der Kuh, andere Tiere, der Mensch oder eine infizierte Umgebung. Schwach infizierte Milchkühe, die die Bakterien nur in unregelmäßigen Intervallen ausscheiden und bei einer mikrobiologischen Kontrolle nicht aufgedeckt werden müssen, stellen eine dauerhafte Infektionsquelle in der Herde dar. Praktisch bedeutet dass, dass jede Milchkuh, die aus einer Herde stammt, in der S. agalactiae vorkommt, als infektionsverdächtig gilt.
Klinische Symptome einer Mastitis, die von S. agalactiae verursacht wird, sind vielfältig. Aus latenten und subklinischen Formen kann sich nach der Geburt häufig eine akute, katarrhöse Mastitis entwickeln.
Auf dem ClearMilk Test wächst Streptococcus agalactiae innerhalb von 24 Stunden nach dem Auftragen der Milch auf die Petrischale, und zwar in kleinen, blaugrünen Kolonien. Danach kann das Testergebnis in unserem Labor mit dem Gerät MALDI TOF kontrolliert werden und vor allem muss die Antibiotikaempfindlichkeit bestimmt werden. Aus der Sicht eine korrekten Praxis bei der antibiotischen Therapie sollten je nach dem Ergebnis des Antibiogramms Antibiotika mit einem spezifisch engen Wirkungsspektrum eingesetzt werden, um so der Entstehung von Resistenzen vorzubeugen, z. B. Benzylpenizillin.